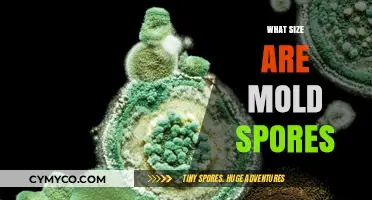
Unveiling the Microscopic World: The Size of Mold Spores Explained

Liverworts, which belong to the division Marchantiophyta, are non-vascular plants that reproduce both sexually and asexually. One of the methods of asexual reproduction in liverworts involves the production of spores. These spores are typically generated in structures called sporangia, which are found on the underside of the liverwort's thallus. When the sporangia open, the spores are released and can be dispersed by wind, water, or animals. Upon landing in a suitable environment, the spores can germinate and develop into new liverwort plants. This method of reproduction allows liverworts to spread efficiently and colonize new areas.
Explore related products
What You'll Learn

What is liverwort?
Liverworts are a group of non-vascular plants that belong to the division Marchantiophyta. They are among the simplest and most primitive land plants, lacking true roots, stems, and leaves. Instead, liverworts have a flattened, leaf-like structure called a thallus, which is responsible for photosynthesis, water absorption, and gas exchange. They are typically found in moist, shaded environments such as forest floors, rocks, and soil.
Liverworts reproduce both sexually and asexually. Sexual reproduction involves the production of male and female gametes, which fuse to form a zygote. This zygote then develops into a sporophyte, which produces spores. Asexual reproduction, on the other hand, occurs through the fragmentation of the thallus or the production of specialized structures called gemmae.
One of the unique features of liverworts is their ability to reproduce by spores. Spores are small, lightweight, and can be dispersed over long distances by wind or water. When a spore lands on a suitable substrate, it germinates and develops into a new liverwort plant. This method of reproduction allows liverworts to colonize new areas and adapt to changing environments.
In addition to their reproductive strategies, liverworts have several other interesting characteristics. They are able to absorb water and nutrients directly through their thallus, and they have a unique system of internal structures called air pores that facilitate gas exchange. Liverworts also play an important role in ecosystems by providing habitat and food for various small organisms.
Overall, liverworts are fascinating plants that have adapted to a variety of environments through their unique reproductive strategies and physiological characteristics. Their ability to reproduce by spores is just one of the many interesting aspects of these primitive land plants.
Sowing the Seeds of Sustainability: A Guide to Spreading Morel Spores
You may want to see also
Explore related products

Reproduction methods of liverworts
Liverworts, belonging to the division Marchantiophyta, exhibit a fascinating array of reproductive strategies. While they are often recognized for their ability to reproduce via spores, this is just one facet of their complex life cycle. Liverworts are non-vascular plants that thrive in moist environments, and their reproductive methods are intricately linked to their habitat and ecological niche.
One of the primary reproductive methods of liverworts is through the production of spores. These spores are generated in specialized structures called sporangia, which are typically found on the underside of the liverwort's thallus. The spores are released into the environment and can germinate into new liverwort plants under suitable conditions. This method of reproduction allows liverworts to disperse widely and colonize new areas, contributing to their adaptability and resilience.
In addition to spore reproduction, liverworts also engage in vegetative reproduction. This process involves the fragmentation of the liverwort's thallus, with each fragment having the potential to develop into a new plant. Vegetative reproduction is particularly common in liverworts that inhabit stable environments, where the conditions are consistently favorable for growth. This method enables liverworts to rapidly expand their population and form dense mats, which can be advantageous for nutrient absorption and protection against desiccation.
Furthermore, some liverwort species exhibit a phenomenon known as apomixis, where new plants are produced asexually from the gametophyte generation. This process bypasses the traditional sexual reproduction cycle and allows for the rapid production of offspring that are genetically identical to the parent plant. Apomixis is thought to be an evolutionary adaptation that enables liverworts to reproduce efficiently in environments where sexual reproduction may be less successful.
The reproductive methods of liverworts are not only diverse but also highly specialized, reflecting their unique biology and ecological requirements. Understanding these methods provides valuable insights into the life cycle and evolutionary strategies of these intriguing plants.
Unveiling the Scientist Behind Heat-Resistant Bacterial Spores Discovery
You may want to see also
Explore related products
$9.99 $11.75

Structure of liverwort spores
Liverworts, belonging to the division Marchantiophyta, are non-vascular plants that reproduce both sexually and asexually. One of the key methods of asexual reproduction in liverworts is through the production of spores. These spores are typically generated in specialized structures called sporangia, which are often found on the underside of the liverwort's thallus (the flat, green part of the plant).
The structure of liverwort spores is quite intricate. Each spore is usually a single cell, encased in a protective outer wall. This wall can be smooth or ornamented, depending on the species of liverwort. The spores are often released from the sporangia in large quantities, allowing for widespread dispersal. This dispersal can occur through various means, such as wind, water, or even animal movement.
Once a spore lands in a suitable environment, it can germinate and develop into a new liverwort plant. The germination process typically involves the spore absorbing water, swelling, and then breaking through the protective wall. The cell inside the spore then begins to divide and grow, eventually forming a new thallus.
The ability of liverworts to reproduce via spores is a significant evolutionary advantage. It allows these plants to quickly colonize new areas and adapt to changing environments. Additionally, spore reproduction can help liverworts survive in harsh conditions, as the spores can remain dormant for extended periods until conditions become favorable for growth.
In summary, the structure of liverwort spores is a crucial aspect of their reproductive strategy. These spores are single-celled, encased in protective walls, and are capable of widespread dispersal and germination in suitable environments. This method of reproduction enables liverworts to thrive in a variety of habitats and adapt to changing ecological conditions.
Unveiling the Lifespan of Mold Spores: A Comprehensive Guide
You may want to see also
Explore related products

Dispersal mechanisms of liverwort spores
Liverworts, non-vascular plants found in damp environments, reproduce via spores, a process distinct from seed production in vascular plants. The dispersal of these spores is a critical aspect of their reproductive cycle, ensuring the propagation of the species. Several mechanisms facilitate the spread of liverwort spores, each adapted to the plant's habitat and ecological niche.
One primary dispersal mechanism is wind. Liverwort spores are lightweight and can be carried significant distances by air currents. This method is particularly effective in open environments where wind can move freely. Another mechanism involves water. In aquatic or semi-aquatic habitats, liverwort spores can be dispersed by water flow, either through rain splash or running water. This method is especially useful in densely vegetated areas where wind dispersal might be hindered.
Animals also play a role in liverwort spore dispersal. Spores can adhere to the fur or feathers of animals, which then transport them to new locations. This method, known as epizoochory, is common in habitats where animals frequently come into contact with liverworts. Additionally, some liverwort species have evolved to disperse their spores through explosive mechanisms. When mature, the spore capsules open suddenly, ejecting the spores into the air. This method, known as ballistochory, can be highly effective in ensuring rapid and widespread dispersal.
The structure of the liverwort spore capsule is also adapted for efficient dispersal. The capsules are often elevated on stalks, which helps in catching wind currents. Moreover, the capsules may have specialized openings that control the release of spores, ensuring they are dispersed gradually over time rather than all at once. This staggered release can increase the chances of successful germination and establishment in new locations.
Understanding the dispersal mechanisms of liverwort spores is crucial for studying their ecology and evolution. It provides insights into how these plants have adapted to their environments and how they contribute to the biodiversity of their ecosystems. Furthermore, knowledge of spore dispersal can inform conservation efforts, helping to protect and manage liverwort populations in the face of environmental changes.
Unveiling the Microscopic World: The Size of Mold Spores
You may want to see also
Explore related products

Lifecycle of liverworts involving spores
Liverworts, small but fascinating plants, have a unique lifecycle that involves the production and dispersal of spores. Unlike many other plants that reproduce through seeds, liverworts rely on spores to propagate and continue their species. This process is an essential part of their lifecycle and plays a crucial role in their survival and adaptation to various environments.
The lifecycle of liverworts begins with the formation of spores within specialized structures called sporangia. These sporangia are typically located on the underside of the liverwort's thallus, the flat, leaf-like structure that makes up the majority of the plant's body. As the spores mature, they are released from the sporangia and dispersed into the surrounding environment. This dispersal can occur through various means, such as wind, water, or even animal movement.
Once the spores have been dispersed, they can germinate and develop into new liverwort plants under the right conditions. This typically involves a moist environment and a suitable substrate, such as soil, rock, or decaying organic matter. The spores will sprout into tiny, thread-like structures called protonemata, which will eventually develop into the mature thallus of the liverwort.
One of the unique aspects of liverwort reproduction is the alternation of generations that occurs during their lifecycle. This means that liverworts go through both a haploid (single-celled) and a diploid (double-celled) stage. The haploid stage is represented by the spores, while the diploid stage is represented by the mature liverwort plant. This alternation of generations allows liverworts to adapt to changing environments and increases their genetic diversity.
In conclusion, the lifecycle of liverworts involving spores is a complex and fascinating process that plays a vital role in their reproduction and survival. By understanding this unique aspect of liverwort biology, we can gain a greater appreciation for these small but remarkable plants and their ability to thrive in a variety of environments.
UV Light's Power: Can It Effectively Eliminate Mold Spores?
You may want to see also
Frequently asked questions
Yes, liverworts reproduce by spores. They produce spores in structures called sporangia, which are often found on the underside of the liverwort's thallus.
The process of spore production in liverworts is called sporogenesis. It involves the development of sporangia, which contain the spores that are eventually released for reproduction.
Liverwort spores are typically dispersed by wind. When the sporangia open, the spores are released and can be carried away by air currents to new locations where they can germinate and grow into new liverwort plants.
Liverwort spores require moist conditions to germinate. They also need a suitable substrate, such as soil or rock, and the presence of light. Once these conditions are met, the spores can germinate and develop into new liverwort plants.
No, liverworts are not the only plants that reproduce by spores. Other non-vascular plants, such as mosses and hornworts, also reproduce by spores. Additionally, some vascular plants, like ferns and horsetails, reproduce by spores as well.